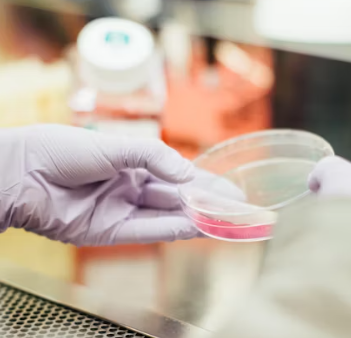
운전면허 신체검사 지정병원&amp;#44; 비용&amp;#44; 항목&amp;#44; 시력&amp;#44; 유효기간

운전면허 신체검사 지정병원, 비용, 항목, 시력, 유효기간 총정리
운전면허 신체검사란?

운전면허 신체검사는 운전을 할 때에 신호등을 보고 교통상황과 주변 상황을 충분히 파악할 수 있는 조건을 갖추고 있는지를 확인하기 위한 검사입니다.
신체검사는 건강검진 결과 내역, 진단서를 제출하면 인정받을 수 있으며, 2년 이내 건강검진표여야 합니다. 단, 1종 대형/특수 면허는 건강검진 내역이 인증되지 않으므로 병원을 방문하여 신체검사를 진행해야 합니다.
운전면허 신체검사 지정병원은 어디인가요?



운전면허 신체검사 지정병원은 도로교통공단 안전운전 통합민원 사이트에서 확인하실 수 있습니다. 각 지역별로 병원명이 나와있으며, 전화번호와 주소도 함께 제공되니, 편리하게 이용하실 수 있습니다.
- 도로교통공단 안전운전 통합민원 사이트에 접속합니다.
- 검색창에 신체검사를 누릅니다.
- 아래 신체검사 발급기관을 누릅니다.
- 지역별 신체검사서 발급기관 아래 원하는 지역을 누르고 찾아봅니다.





운전면허 신체검사 비용은 얼마인가요?
운전면허 신체검사 비용은 지역, 병원, 검사 종류에 따라 다를 수 있습니다. 정확한 비용은 확인하기 위해 해당 병원이나 도로교통공단에 문의하시는 것이 가장 정확합니다. 하지만 일반적으로 운전면허 신체검사 비용은 다음과 같습니다.
- 대형 및 특수 면허 : 7000원
- 그 외 : 6000원
운전면허 신체검사 항목은 무엇이 있나요?
- 신체검사 항목으로는 시력, 청력, 색각 등이 있습니다.
- 시력검사표 앞에 6m 정도 떨어진 거리에 서서 검사자의 지시에 따라 한쪽 눈을 가리고 진행합니다.
- 검사자가 가리키는 숫자나 그림, 표식을 말합니다.
- 안경이나 렌즈를 착용하는 경우 제거된 상태에서 검사를 진행한 후, 착용한 상태에서도 검사를 진행하여 교정시력을 확인합니다.
- 색각 검사는 색각 카드나 색각 검사지 등을 이용하여 진행됩니다.
- 이시하라 색각 검사로 진행합니다. 이 검사표는 정상 색각자들은 쉽게 읽을 수 있지만, 색각 이상자들은 읽기 어려운 시표로 구성되어 있습니다. 이시하라 색각 검사는 숫자와 선으로 된 38장의 시표를 환자가 읽는 방식으로 진행합니다.
운전면허 신체검사 시, 시력 기준이 있나요?
- 1종의 경우 : 양안 시력 0.8 이상, 한 쪽 시력이 0.5 이상이어야 합니다.
- 2종의 경우 : 양안 시력이 0.5 이상이면 됩니다.
운전면허 신체검사 유효기간이 있나요?
운전면험 신체검사의 유효기간은 1년입니다. 다만, 2년 이내에 직장이나 지역의료보험을 적용하여 받은 건강검진내역서는 2년까지 유효합니다.
운전면허 신체검사받을 때, 필요한 준비물은?
운전면허 신체검사를 받을 때, 필요한 준비물은 운전면허증, 신분증, 사진 등이 있습니다. 정확한 준비물을 확인하기 위해 해당 지역의 운전면허 시험장이나 경찰서에 문의해 보시는 것이 좋습니다.
- 신분증
- 응시원서
- 6개월 이내 촬영한 컬러 사진 (규격 3.5cm * 4.5cm) 1매
건강검진 결과가 있다면 신체검사를 받지 않아도 됩니다.
나이가 들어도 운전면허 신체검사할 때, 다른 기준이 없나요?
나이가 들어도 운전면허 신체검사의 변화는 없습니다.
- 시력 : 교정시력 포함 좌, 우 둘다 0.8 이상이어야 합니다. (1종과 2종 다름)
- 색채식별 : 적색, 녹색, 노란색을 구별할 수 있어야 합니다.
- 청력 : 55데시벨의 소리를 들을 수 있어야 합니다.
색채식별 검사는 운전자가 주변 환경을 정확하게 인식하고, 다른 차량이나 보행자 등의 존재를 인식하는데 중요한 역할을 합니다. 쉽게 말해, 운전면허 신체검사에서 색채식별 검사를 하는 이유는 운전 시, 신호등의 색깔인 빨간색, 초록색, 노란색을 구별할 수 있는지 여부를 확인하기 위함입니다. 이는 안전한 운전을 위해 매우 중요한 요소 중 하나이기 때문입니다.
1종 대형 또는 특수차량과 관련된 면허증의 경우, 시력, 색채식별, 청력, 운동능력이 필요하며, 1종 보통이나 2종 면허(신규발급)에는 시력검사만 진행하면 됩니다.


댓글